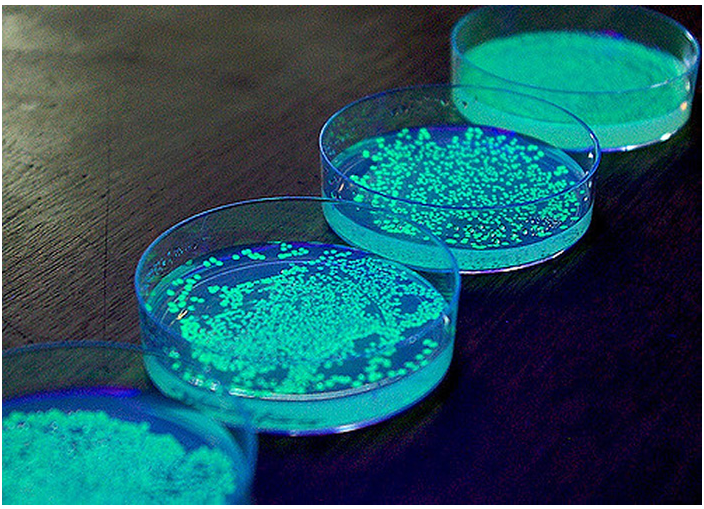
image.png

技術文章
更新時間:2025-12-26
點擊次數:12
對于高強度的實驗室級的紫外線燈您會選擇嗎?
市面上通用的高強度紫外線燈都是功率為100瓦的高壓汞燈,可傳統的高壓汞燈都帶有比較沉重的鎮流器,工作中也會產生高溫,容易對作業人員造成燙傷。另外根據國際組織《水俁條約》規定,到2020年為止,禁止水銀電池及熒光燈的生產與進出口貿易。如果您選購100w的傳統高強度紫外線燈,那么到2020年底,您將有可能買不到100w的紫外線燈泡,沒有了100W的紫外燈泡替換,那么您的高強度紫外線燈也就無法使用了,所以您還選用傳統的100w高強度紫外線燈嗎?
替代傳統100W高壓汞燈的就是新款LUYOR-3410 LED便攜式高強度紫外線燈,LED冷光源,沒有沉重的鎮流器,單手操作無壓力,強度高。光譜純正,同樣可以滿足在科研院所、高校生命科學的轉基因熒光蛋白篩選和分子材料的光催化反應的應用。另外還有UV固化,食品污染檢測,齒科動物污染檢查,E-大腸桿菌實驗,潔凈室檢驗等等實驗。
新款LED型LUYOR-3410便攜式高強度紫外線燈由上海熙浩實業有限公司代理銷售,冷光源,LED強度高,重量輕,并享有三年質保。讓您后期使用維護成本直降到零。
LUYOR-3410便攜式高強度紫外線燈與傳統100瓦高壓汞燈的參數對比說明:

LUYOR-3410便攜式高強度紫外線燈與傳統100瓦高壓汞燈的外觀對比說明:

傳統100W高壓汞燈能做到的實驗,LUYOR-3410高強度紫外線燈可以替代。讓我們來看看LUYOR-3410的技術參數和做實驗的效果圖:
LUYOR-3410實驗室用高強度紫外線燈的技術參數:
功率:紫外15w,白光:5w。紫外強度:380mm處紫外線強度為8,000uW/cm2。尺寸:200x180mm,頭部直徑120mm,質量:0.8kg。波長:360-370nm 主峰365nm。配有支架,解脫雙手,可24小時連續工作(支架為選配)。在38mm距離處,可產生大約直徑150mm的高強度紫外光斑。
LUYOR-3410高強度紫外線燈用于觀察煙草葉片gfp的表達:

LUYOR-3410高強度紫外線燈用于觀察礦石的顏色:

LUYOR-3410高強度紫外線燈用于菌落的GFP表達: